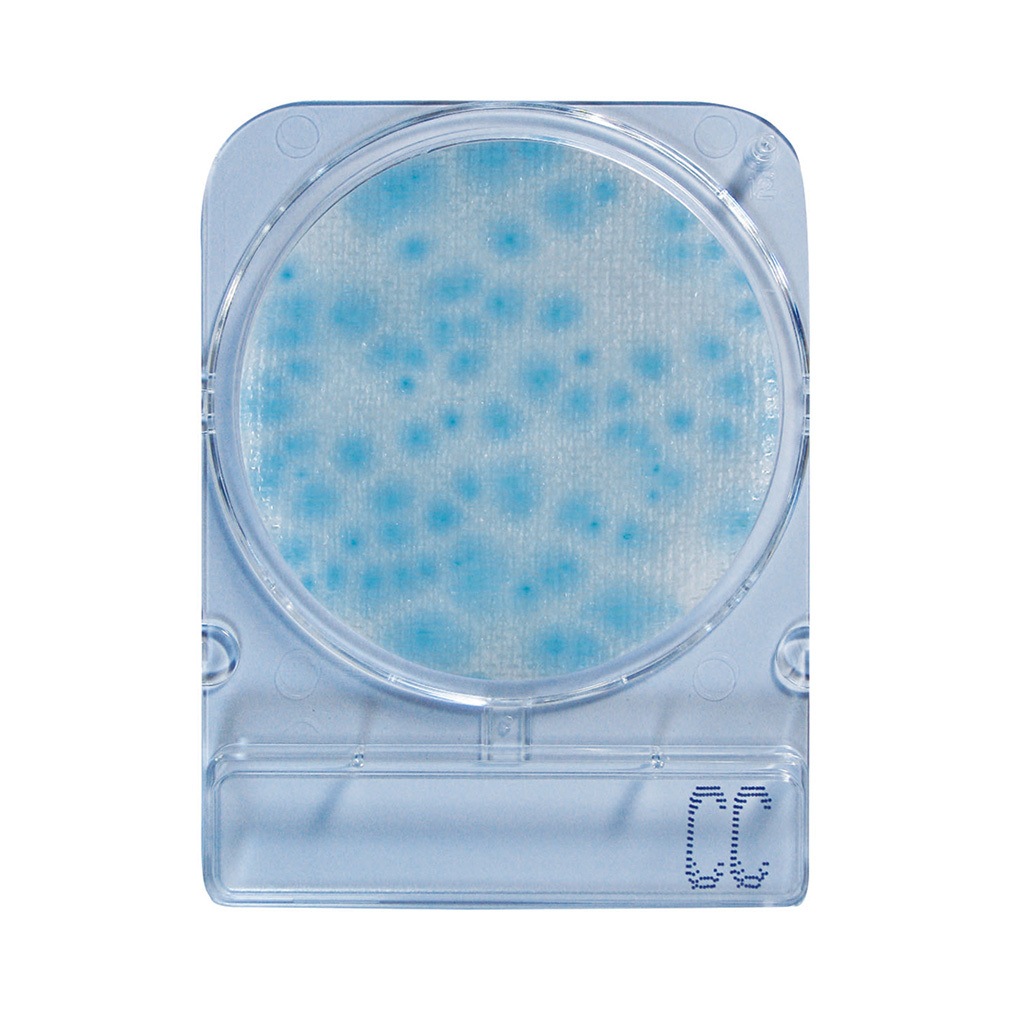
04299 コンパクトドライ 1箱(60袋×4枚) 島津ダイアグノスティクス 【通販モノタロウ】

ドラレコ用として購入しました。
128gbでこの価格は満足です。
まだ解らないが使用始めてから、どのくらいの時間
で寿命を迎えるのか今の所お試しといったところです。
プライム無料体験をお試しいただけます
プライム無料体験で、この注文から無料配送特典をご利用いただけます。
| 非会員 | プライム会員 | |
|---|---|---|
| 通常配送 | ¥410 - ¥450* | 無料 |
| お急ぎ便 | ¥510 - ¥550 | |
| お届け日時指定便 | ¥510 - ¥650 |
*Amazon.co.jp発送商品の注文額 ¥3,500以上は非会員も無料
無料体験はいつでもキャンセルできます。30日のプライム無料体験をぜひお試しください。
| ブランド | ホイール |
| 無線通信会社 | すべてのネットワーク接続業者 |